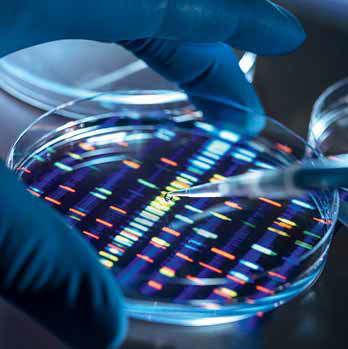

Новая жизнь биотехнологий
Биотехнологии стали драйвером развития фармацевтики, медицины, пищевой промышленности и сельского хозяйства. В России после ухода западных компаний многие направления биотеха придется создавать почти с нуля, что потребует поддержки государства.

Постоянно мутирующие вирусы, продовольственный дефицит и экологические проблемы в последние годы сделали биотехнологии одним из востребованных и быстро развивающихся сегментов экономики. В 2022 году, по данным Precedence research, его глобальный объем оценивался в $860 млрд, и, как ожидается, к 2030 году этот показатель вырастет почти в два раза, до $1,68 трлн. Средний рост в течение следующих семи лет составит около 8,7% в год. В свою очередь, Mordor Intelligence прогнозирует еще более высокие ежегодные темпы развития индустрии биотехнологий— 15% до 2026 года. Основная доля выручки в общем объеме биотехнологий в 2022 году приходилась на Северную Америку (37,8%) и Азиатско-Тихоокеанский регион (23,8%).
Несчастье помогло
По оценкам экспертов, более половины всех биотехнологий сконцентрировано в области фармацевтики и здравоохранения. После 2020 года огромный стимул для развития рынка биотехнологий дала пандемия COVID-19, которая потребовала масштабных усилий по разработке вакцин, высокопрогнозирующих тестов на антитела, перепрофилированию существующих противовирусных препаратов и разработке новых лекарств.
Как поясняет декан факультета биоинженерии и биоинформатики МГУ Андрей Замятнин, на данный момент в мире продолжается бум использования антител. «На рубеже веков молекулярная биология стала молекулярной медициной, когда появилось жесткое требование, чтобы у каждого лекарства была своя мишень и доказанный механизм действия. Очевидно, что создание терапевтических антител против таких мишеней является одним из эффективнейших биотехнологических подходов при разработке новых лекарств. Однако антитело — это достаточно большая молекула, у которой из-за этого может быть снижена эффективность, так что следующим шагом стало использование фрагментов антитела с той же целью — специфического распознавания определенной мишени», — говорит он.
Другими передовыми направлениями в области медицины, по словам эксперта, являются генная терапия и регенеративная медицина, которая предполагает выращивание органов для их последующей трансплантации. Фармацевтика — самая зарегулированная область биотехнологий, с учетом того что разработка лекарств — это дорогой и долгий процесс, отмечает Андрей Замятнин.
Глава инжинирингового центра «МИЦ» Ратмир Дашкин согласен, что биотехнологии — инструмент будущего, позволяющий решать проблемы питания, лечения и экологии. Одно из наиболее перспективных направлений, по его мнению, на данный момент — разработки в области моноклональных антител (МАТ; секретируются иммунными клетками, происходящими от единственной антителообразующей клетки), препараты на их основе сейчас являются самыми перспективными в лечении онкологических заболеваний, и они производятся на территории страны.
Елена Анискина, эксперт по развитию бизнеса компании «АС РС», производителя неденатурированного нативного коллагена, указывает, что с 2008 года к 2022-му доля биотехнологий на мировом фармацевтическом рынке выросла с 17 до 28% и эта динамика будет только ускоряться.
Руководитель биотехнологического кластера АО «Технопарк Новосибирского академгородка» Мария Галямова добавляет, что не стоит забывать о сельскохозяйственных биотехнологиях, на которых завязано обеспечение продовольственной независимости. Это и обеспечение страны собственным семенным материалом, и работа с генофондом сельскохозяйственных животных, и разработка комплексных систем производства продуктов питания по принципу «все свое» (посадочный материал, технологии выращивания, технологии переработки) с применением биотехнологических продуктов, обеспечивающих экологичность, качество и экономическую эффективность финального продукта питания, поясняет она.
Перспективы на старте
Фармацевтическую отрасль биотехнологий России также придется создавать фактически с нуля, с учетом того что до настоящего времени до 80% объема медицинских изделий и сырья для медицины и фармацевтики, включая действующие вещества и интермедиаты для синтеза фармсубстанций, приобреталось у западных партнеров, отмечает Елена Анискина.
Эксперты сходятся во мнении, что санкции позитивно повлияют на построение национального сектора биотехнологий, но ключевая роль в этом процессе должна принадлежать государству. «Господдержка жизненно необходима. Если правительство готово поддерживать и оказывать помощь уже существующим наработкам, лоббировать внедрение инноваций, это уже сильно простимулирует бизнес», — отмечает Елена Анискина. По ее мнению, одним из важнейших аспектов поддержки является обновление законодательства, чтобы нормативы учитывали инновации, а также устранение ошибок в действующих законах, снятие регуляторных ограничений на развитие биотеха.
Другим аспектом, отмечает Мария Галямова, является финансовая помощь, поскольку «порог входа» в биотехнологический бизнес остается высоким: необходимы серьезные вложения в инфраструктуру, длительные циклы НИОКР. По ее мнению, речь может идти о специальной программе для комплексных проектов, программе стимулирования спроса на биотехнологическую продукцию. Кроме того, говорит она, необходим координационный орган, который позволит суммировать и усиливать биотехнологические инициативы в различных отраслях. В идеале это федеральная программа развития биотехнологий.
Андрей Замятнин полагает, что для комплексного развития сектора фармацевтических биотехнологий есть смысл создать соответствующую государственную корпорацию «Росфарма». В настоящее время, отмечает он, в России за счет различных госпрограмм фармкомпании уже достаточно неплохо освоили производство дженериков и биоаналогов. По мнению декана, если же говорить об инновационных и оригинальных препаратах, то с учетом резко возрастающих рисков и стоимости их разработки развивать эти направления без поддержки государства компаниям невыгодно.
Ратмир Дашкин согласен, что есть направления, по которым в России уже существует достаточно сильная база, например получение вакцин. Также, говорит он, ведется работа по локализации в стране производства одноразового ферментационного оборудования для производства данных препаратов (моноклональных антител или вакцин). Наиболее доступным эксперт называет строительство мощностей под продукцию с коротким периодом жизни (например, вакцины или моноклональные антитела) или производство товаров с очень долгим сроком жизни (например, лимонная кислота). В то же время запуск производства полностью инновационного продукта не всегда оправдан, так как высоки риски неудачи с учетом затрат на строительство завода в десятки миллиардов рублей и сроков строительства в семь — десять лет. «Получаемая продукция должна быть конкурентна на мировом рынке. Малейший просчет в технологии недопустим — именно поэтому многие компании предпочитают покупать готовые и проверенные товары. Но создание собственных компетенций по запуску новых производственных мощностей, включая разработку технологий, технологический инжиниринг, изготовление оборудования, — единственный путь, позволяющий решать критические задачи в кратчайшие сроки и конкурировать на международной арене», — говорит Ратмир Дашкин.
Мария Галямова, однако, поясняет, что тезис о том, что биотехнологическое производство — это очень дорогая инфраструктура, которая оправданна только на «большом масштабе», далеко не всегда является верным. Помимо масштабных производств, например кормовых ферментов, аминокислот, благодаря новым технологиям появляются возможности запуска, скажем, на ферме биогазовой установки для переработки отходов. «Это тоже вполне доступная биотехнология, не требующая масштабных инвестиций», — говорит она, подчеркивая, что сегодня биотехнологии могут быть применимы на предприятиях любого масштаба.
Сегодня устойчивый ESG-тренд формирует потребитель
Григорий Шифрин, сооснователь ООО «Салпама»
Понятие устойчивого развития внедрилось в нашу жизнь настолько глубоко, что отменить этот тренд не смогли никакие внешние потрясения. Одна из причин — фокус экоинициатив сместился в область потребления: теперь конечный потребитель информирует бизнес о том, что ему важно, как будут жить будущие поколения.
В 2022 году к растущему рынку зеленых сертификатов и углеродных единиц подключилось и государство рядом законодательных инициатив. Назначен официальный оператор реестра углеродных единиц — ООО «Контур». Официальный регулятор рынка зеленых сертификатов пока не выбран. Мы вошли на этот рынок немного раньше, создав компанию «Салпама», цель которой — обеспечение юридических и физических лиц инструментами снижения углеродного следа. Компания разработала свой стандарт требований к качеству системы отслеживания выбросов углерода в соответствии с лучшими международными практиками и создала систему сертификации, объединяющую климатические проекты от производства зеленой энергии до поглощения СО2. Также «Салпама» предоставила ООО «Контур» для повсеместного пользования две собственные методики, разработанные совместно с ФГБУ «ИГКЭ им. Ю.А. Израэля».
Основной посыл ESG-целей ООН — признание существования неразрывной связи между безопасной окружающей средой и социально-экономическим развитием. Достижение этих целей предполагает постоянный поиск бизнесом наиболее эффективных экономических и экологических решений. Поддержка государством этого направления наверняка будет расширяться. В финансовой сфере пока только «Сбер» начал практику зеленых кредитов. Но скоро конечный потребитель заставит и другие финансовые институты России подхватить эту инициативу и запустить процесс.
От египетского пива до генетических лекарств
Биотехнология — отрасль науки, продукты в которой разрабатываются и создаются с использованием биологических систем, микроорганизмов, живых существ или их элементов. История развития методик применения природных компонентов для создания новых товаров насчитывает несколько тысячелетий. Первым опытом в этой области можно считать выпекание хлеба в Месопотамии, пивоварение в Египте, виноделие и сыроварение в Греции и Римской империи.
В XIX веке развитие биотехнологий перешло на следующий этап и ускорилось благодаря технической революции и активной механизации процессов. Это направление от опытного метода перешло к научному подходу, стали формироваться отдельные сегменты, такие как генетика, микробиология и вирусология. Наиболее существенным прорывом на тот момент в области биотехнологий стало открытие и запуск в производство витаминов и ферментов.
Сегодня ежегодно разрабатываются новые технологии и продукты в медицине, сельском хозяйстве и промышленной биотехнологии. В течение последнего десятилетия быстро развивались такие передовые методы, как геномный анализ, позволяющий на микробиологическом уровне идентифицировать генетические изменения при диагностике основных инфекционных заболеваний, в том числе ВИЧ, малярию и туберкулез, а также генетические аномалии. Увеличение глобальной распространенности целевых заболеваний наряду с продемонстрированной полезностью анализа полимеразной цепной реакции (ПЦР) в диагностике и оценке болезнетворных бактерий приведет к расширению использования клинических диагностических тестов и в конечном счете будет способствовать росту рынка биотехнологий в ближайшие годы, отмечают в Precedence research.
Фото: пресс-служба, Getty Images Russia